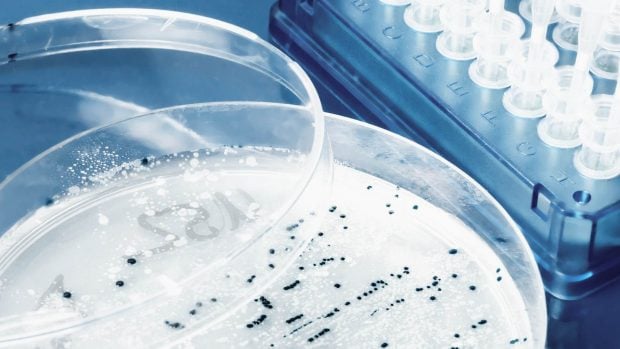
laboratorio plásticos

La unión hace la fuerza: descubren cómo las bacterias se alían para devorar los plásticos del mar
Investigadores del MIT identifican cinco bacterias capaces de degradar completamente el plástico
El hallazgo abre la puerta a nuevos sistemas de reciclaje microbiano del plástico en los océanos

Las bacterias y los plásticos protagonizan uno de los descubrimientos más prometedores del año en la lucha contra la contaminación marina. Un equipo de investigadores del MIT ha identificado cómo cinco especies de bacterias oceánicas se complementan para descomponer un plástico biodegradable de uso común. El hallazgo, publicado en la revista Environmental Science and Technology, abre la puerta a nuevos sistemas de reciclaje microbiano.
Más de la mitad del plástico producido en el mundo acaba en vertederos o se vierte directamente al medioambiente. Ante este escenario, los plásticos biodegradables se presentan como una solución, pero hasta ahora se sabía muy poco sobre cómo y con qué rapidez los microorganismos los descomponen. El estudio del MIT arroja luz por primera vez sobre ese proceso oculto.
El plástico del campo y la cocina
Los investigadores analizaron un tipo de plástico conocido como co-poliéster alifático aromático, empleado en bolsas de la compra, envases de alimentos y mantas agrícolas para controlar malezas y conservar la humedad del suelo.
Para iniciar el experimento, la empresa química BASF sumergió muestras de este material a distintas profundidades del Mediterráneo. Las dejaron colonizar por bacterias durante semanas antes de enviarlas al laboratorio.
Una vez en el MIT, el equipo aisló el mayor número posible de especies bacterianas y seleccionó las 30 que crecían con mayor abundancia sobre el plástico. A través de un proceso de eliminación y combinación, los investigadores redujeron esa comunidad compleja a tan sólo cinco bacterias que degradaban el material con la misma eficacia que las 30 juntas.
La bacteria que rompe el polímero
El papel clave lo desempeñó la bacteria Pseudomonas pachastrellae, la única capaz de despolimerizar el plástico y romperlo en sus tres componentes químicos: ácido tereftálico, ácido sebácico y butanodiol. Sin embargo, esta bacteria no podía consumir los tres subproductos por sí sola. Las otras cuatro bacterias identificadas se repartían esa tarea de forma complementaria.
«Es muy raro que una sola bacteria lleve a cabo todo el proceso de degradación, porque requiere una carga metabólica significativa», explica Marc Foster, autor principal del estudio y estudiante de doctorado en el programa conjunto MIT-WHOI. La investigación demuestra que las bacterias y el plástico mantienen una relación de degradación altamente dependiente de la comunidad microbiana presente en cada entorno.
Ninguna puede sola
Cuando los investigadores retiraron una sola bacteria de las cinco, la mineralización caía de forma notable. Y cuando cada bacteria se cultivaba por separado, ninguna lograba alcanzar el nivel de degradación del grupo completo. Este resultado confirma que la colaboración entre bacterias no es un accidente, sino una necesidad biológica para eliminar los plásticos del entorno.
Otro hallazgo relevante fue que esta misma comunidad de cinco bacterias no fue capaz de mineralizar distintos tipos de plásticos. Esto sugiere que las especies especializadas no son generalistas: su eficacia depende tanto de la comunidad microbiana local como de la composición química concreta del polímero.

Vida útil incierta
«Muestra que la biodegradación del plástico es muy dependiente de la comunidad microbiana donde acaba el material», señala Foster. La velocidad de degradación también varía según la química del polímero y el modo en que se ha fabricado el producto, lo que complica las predicciones sobre la vida útil real de estos materiales en el medioambiente.
«Hay mucha ambigüedad sobre cuánto tiempo existen realmente estos materiales en el entorno», añade el investigador. Sin conocer los detalles específicos de cada proceso de degradación, no será posible predecir con precisión la vida de los plásticos ni controlar mejor su descomposición en ecosistemas marinos y terrestres.
Hacia el reciclaje microbiano
El equipo del MIT considera este trabajo un primer paso esencial hacia el diseño de sistemas microbianos más eficientes para degradar plásticos o convertirlos en materiales útiles. Foster continúa investigando qué combinaciones de bacterias resultan más efectivas para acelerar el consumo de plástico y cómo las enzimas se adhieren a las partículas para iniciar y mantener el proceso de degradación.
El estudio, financiado por el MIT Climate and Sustainability Consortium y BASF, establece una hoja de ruta científica para aprovechar la capacidad natural de las bacterias frente al plástico. Si los investigadores logran replicar y escalar estos mecanismos, la microbiología podría convertirse en una herramienta decisiva en la lucha global contra la contaminación de los océanos y de los ecosistemas terrestres.